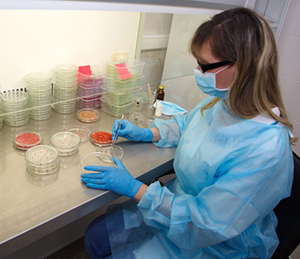

Что учесть перед протравливанием зерна
В последние сезоны погода во всех регионах возделывания озимых раз за разом преподносит хлеборобам сюрпризы. Центральная Россия, где наращивают производство продовольственного зерна, – не исключение. Редакция попросила менеджера-технолога представительства компании «Август» в г. Саранске Андрея САВЕЛЬЕВА рассказать о складывающейся в регионе фитосанитарной обстановке и в связи с этим – о правильной подготовке к озимому севу.
 В ряде регионов Центральной России из-за засухи прошлого года озимые ушли в зиму 2019 года ослабленными. Затем весенняя жара затормозила развитие растений и не дала им раскуститься как следует. Во многих областях, в том числе и в Мордовии, посевы озимой пшеницы получились изреженными, и больших урожаев ждать не приходится. Другая беда – недостаток влаги в почве. Несмотря на обильный снежный покров зимой, от его таяния в метровом слое оказалось лишь от 80 до 140 мм воды. Майские осадки, прошедшие в некоторых регионах, состояние озимых радикально не улучшили. Поэтому в этом сезоне во многих местах, в том числе и в Мордовии, озимые по продуктивности будут хуже яровых, а где-то дадут примерно сопоставимый с ними результат. И в такой ситуации многие хозяйства отказываются от химобработок: исключают фунгициды, потому что затраты на них могут не окупиться, а кто-то по той же причине отказывается и от инсектицидов. И зря! Ведь все проблемы непременно скажутся на посевных качествах семян и на урожае следующего года.
В ряде регионов Центральной России из-за засухи прошлого года озимые ушли в зиму 2019 года ослабленными. Затем весенняя жара затормозила развитие растений и не дала им раскуститься как следует. Во многих областях, в том числе и в Мордовии, посевы озимой пшеницы получились изреженными, и больших урожаев ждать не приходится. Другая беда – недостаток влаги в почве. Несмотря на обильный снежный покров зимой, от его таяния в метровом слое оказалось лишь от 80 до 140 мм воды. Майские осадки, прошедшие в некоторых регионах, состояние озимых радикально не улучшили. Поэтому в этом сезоне во многих местах, в том числе и в Мордовии, озимые по продуктивности будут хуже яровых, а где-то дадут примерно сопоставимый с ними результат. И в такой ситуации многие хозяйства отказываются от химобработок: исключают фунгициды, потому что затраты на них могут не окупиться, а кто-то по той же причине отказывается и от инсектицидов. И зря! Ведь все проблемы непременно скажутся на посевных качествах семян и на урожае следующего года.
ВАЖНОСТЬ ЗАЩИТЫ
Показатели всхожести получаются самыми высокими только у крупного и выровненного зерна. А оно формируется таким только при хорошей работе листового аппарата, которому не мешают болезни. Защита растений от заболеваний и подкормки по листу – азотные, комплексные, микроэлементные – помогают зерну стать более крупным и здоровым.
Негативно влияют на качество семян и вредители, в первую очередь с колюще-сосущим ротовым аппаратом: трипсы, тля, а также злаковые клопы. У трипса ротовой аппарат маленький, и его личинки высасывают соки только из поверхностных клеток. Присутствие этих насекомых на озимой пшенице на уровне ЭПВ способно снизить продуктивность культуры на 8 - 12 %. Но самое главное – трипс наносит зерновке микроповреждения, загрязняет ее поверхность экскрементами и создает входные ворота для инфекций.
И это еще не все! В конце периода созревания зерна, после того как пройдут дожди, в зерне включается процесс гидролиза запасенных крахмалов и белков, и полученные вещества через оставленные трипсами микротравмы начинают «стекать» на поверхность зерновки. В результате поверхность колоса и семян заселяется сапрофитными и полупаразитными грибами: Alternaria, Cladosporium, Epicoccum и другими. Происходит так называемое энзимо-микозное истощение семян (Темирбекова С. К., 1997): зерновка становится щуплой и теряет всхожесть.
Озимую пшеницу могут повреждать несколько видов тли. Эти насекомые обычно питаются в среднем и нижнем ярусах растений пшеницы. Но когда их численность переваливает за определенный рубеж, то тля повреждает и колос. Каждое насекомое высасывает сок, усваивает из него белки и минеральные вещества, а лишние углеводы выбрасывает, оставляя на всех поверхностях растения сахаристые выделения (падь). И на таком богатом источнике энергии начинают развиваться сапрофитные и полусапрофитные грибки, которые вызывают симптомы черни колоса, а также начинается всплеск развития разных видов альтернарии, причем при проведении фитоэкспертизы количество этого патогена просто зашкаливает. Такая ситуация характерна не только для текущего сезона: она повторяется из года в год.
ЗЕРНО ДОЛЖНО СОЗРЕТЬ
Большинство площадей озимых у нас полностью засевают, как говорят, «из-под комбайна», то есть свежеубранным зерном, которое без промедления очищают, протравливают и тут же сеют. А ведь семенам зерновых после уборки требуется хотя бы две - три недели, чтобы созреть, тогда и всхожесть повышается. Сушка и подработка ускоряют эти процессы.
В советские годы было принято оставлять страховые и переходящие фонды зерна, то есть больше сеяли семенами прошлого года. Зерно в таких фондах было заранее подработано и высушено, так что у хозяйств была возможность своевременно и без спешки провести протравливание свежих партий семян. Это значительно облегчало работу, так как всего 20 - 30 % от общей потребности готового семенного материала для озимого сева уже обеспечивает равномерное и планомерное проведение всех этапов подготовки семян. У хозяйства появляется время выдержать свежеубранное зерно, не задерживая посевные работы. Переходящий фонд семян позволял снизить естественный инфекционный фон и практически полностью подавить развитие спорыньи (на ржи, реже – на пшенице), так как склероции спорыньи на второй год не прорастали.
К сожалению, в наше время многие хозяйства отошли от этой испытанной практики. И в результате у нас повсеместно из года в год высевают зерно, которое даже не успело пройти стадию физиологического созревания и изначально имеет низкую энергию прорастания.
ПРАВИЛЬНЫЙ ПРОТРАВИТЕЛЬ
Фитоэкспертиза – обязательный подготовительный элемент посевной кампании. Она позволяет не только оценить состав патогенных микроорганизмов на зерне (и потенциально – в поле), выбрать эффективный протравитель, а также сделать «работу над ошибками». Скажем, если мы задерживаемся с уборкой, зерно перестаивает, и на нем в основном «выскакивают» грибы родов Cladosporium, Epicoccum, Alternaria. А на убранном, но не доработанном вовремя зерне, которое лежало в кучах, обнаруживаются Penicillium и Aspergillus. Фитоэкспертиза также позволяет нам оценить целесообразность удорожания протравочных схем, выбора протравителя из другого ценового класса или уровня эффективности.
Фитоэкспертиза – обязательный подготовительный элемент посевной кампании. Она позволяет не только оценить состав патогенных микроорганизмов на зерне (и потенциально – в поле), выбрать эффективный протравитель, а также сделать «работу над ошибками». Скажем, если мы задерживаемся с уборкой, зерно перестаивает, и на нем в основном «выскакивают» грибы родов Cladosporium, Epicoccum, Alternaria. А на убранном, но не доработанном вовремя зерне, которое лежало в кучах, обнаруживаются Penicillium и Aspergillus. Фитоэкспертиза также позволяет нам оценить целесообразность удорожания протравочных схем, выбора протравителя из другого ценового класса или уровня эффективности.
Такую услугу оказывают во многих местах. Можно обратиться в Россельхозцентр или семенную инспекцию. В лабораториях «Агроанализа» компании «Август» она тоже есть. У нас все анализы выполняются по гостированным методикам, поэтому результатам можно доверять и смело руководствоваться ими для внутреннего использования.
При низкой степени поражения инфекцией можно использовать простые одно- или двухкомпонентные протравители. Зачастую ситуацию спасет одно проверенное действующее вещество (д. в.) широкого спектра действия – тебуконазол, который справляется и с головневыми болезнями, и с корневыми гнилями, если там их мало, а также эффективно подавляет альтернарию. Он действует и системно, и контактно. Препаратов на основе тебуконазола немало. Например, это Бункер, а также проверенный временем Виал ТрасТ, который долгие годы был основной «рабочей лошадкой» при протравливании. До сих пор по своему составу (тебуконазол + тиабендазол) он не утратил актуальности и по сей день успешно применяется в большинстве регионов. Также хорошим и достаточно длительным действием обладает ципроконазол, который входит в состав препарата Виал Трио.
Еще одно д. в. из класса триазолов, которое набирает популярность в составе протравителей, – дифеноконазол. В протравителе Оплот он сочетается с тебуконазолом, и это ставит данный продукт в ряд самых эффективных и коммерчески привлекательных.
Чем выше степень развития патогенных микроорганизмов на семенах, тем более «сильные» препараты нужно брать для протравливания. Если мы планируем семенные посевы, то лучше сразу закладывать применение трехкомпонентного протравителя.
Можно комбинировать препараты самостоятельно. Например, смесь фунгицидных и инсектицидных протравителей Бункер, Синклер, Табу обладает широким спектром активности, контактным и системным действием.
УЧТИТЕ ПОБОЧНЫЕ ДЕЙСТВИЯ
Многие триазольные препараты обладают ретардантным действием, которое надо учитывать. Обычно озимая рожь выносит узел кущения к поверхности, а пшеница располагает его на глубине 2 - 2,2 см, даже если семена посеяны на глубину 5 - 6 см. Это происходит благодаря подземному междоузлию. Однако под влиянием триазолов оно укорачивается, и узел кущения при этом закладывается глубже, чем нужно. На тяжелых суглинистых и заплывающих почвах это минус, потому что зерно прорастает медленно и, соответственно, дольше находится под давлением неблагоприятных экологических факторов (энергия прорастания и полевая всхожесть могут снизиться). Поэтому на таких почвах лучше применять препараты без ретардантного эффекта, но со стимулирующим действием на семена – например, содержащий дифеноконазол Оплот. С другой стороны, более глубокая закладка узла кущения обеспечивает лучшую влагообеспеченность культуры, увеличивает зимостойкость озимых культур.
СОБЛЮДАЙТЕ РЕГЛАМЕНТЫ
Для каждого препарата разработаны подробные рекомендации, и исполнители должны быть в курсе необходимости их соблюдения. Менеджеры «Августа» всегда готовы ответить на любые вопросы по этой теме! В целом же необходимо обратить внимание на несколько важных пунктов.
Подготовка зерна. Его весьма желательно калибровать, потому что в одинаковых по массе порциях крупные семена имеют меньшую относительную площадь поверхности и связывают меньше препарата по сравнению с мелкими. Это очень важно не только для качественного протравливания, но и помогает в дальнейшем получить дружные всходы с равномерным развитием.
Количество битых зерновок и инородных частиц должно быть не более 0,5 - 1 %, чтобы сор и пыль не впитывали протравитель. Для очистки зерна от пыли перед протравливанием желательно выполнить аспирацию.
Стоит соблюдать температурный режим рабочего раствора при протравливании (в среднем около 20 °С), хотя для озимых культур отклонения допускаются.
Очень важно строго придерживаться норм расхода препарата и контролировать количество протравителя на семенах. К сожалению, эффективной экспресс-диагностики его определения пока не существует. Хотя есть компании, которые предлагают следить за количеством примененного препарата на зерне путем смыва и колориметрического анализа. Но такие методы совершенно непригодны для баковых смесей (разные компоненты отличаются по цвету), имеют много других ограничений и нередко носят характер маркетинговых шоу. Так что полностью доверять им не стоит: они весьма косвенны и приблизительны.
Правильные результаты дают исследования по стандартной методике – отбор образцов и определение количества д. в. в лабораториях Россельхозцентра методом газовой или жидкостной хроматографии. Удовольствие это стоит денег и требует профессионализма сотрудников, но пока ничего лучше не придумано, а без его результатов протравливание будет идти вслепую. Поэтому мы не только всегда рекомендуем нашим партнерским хозяйствам не пренебрегать таким исследованием, но сами помогаем отбирать образцы протравленного зерна и передавать в лаборатории Россельхозцентра. Это дисциплинирует и нас, и хозяйства. К тому же, если такой анализ выполнить в начале протравочной кампании, его результаты позволяют оперативно скорректировать работу протравочных машин и сделать процесс более эффективным.
Подготовили Елена ПОПЛЕВА, Виктор ПИНЕГИН
Контактная информация
Андрей Сергеевич САВЕЛЬЕВ
Тел. моб.: (927) 276-70-81
Контактная информация
Лаборатория «Агроанализ-Центр»
Тел.: (47461) 3-51-06
Опубликовано в номере 7 за 2019 год
Перепечатка и копирование материалов на электронные ресурсы только с письменного разрешения редакции и с указанием первоисточника.


